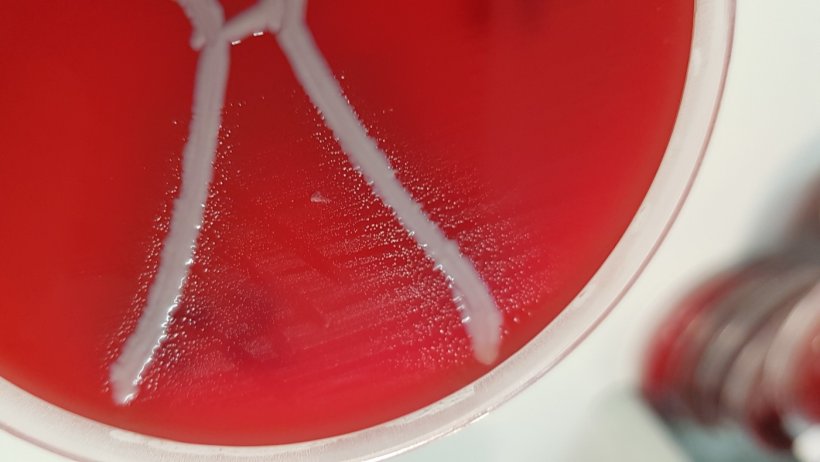
Glaesserella australis on blood plate with Staphylococcus aureus displaying satellitism. Source: QAAFI

A Queensland Alliance for Agriculture and Food Innovation (QAAFI) descobriu uma nova espécie de bactéria infecciosa no pulmão de suínos, a Glaesserella australis.
G. australis está associado a dois cenários de doenças. No primeiro cenário não há sinais clínicos aparentes de doença na granja, mas no matadouro a carcaça apresenta lesões e abscessos nos pulmões muito semelhantes aos causados pelo Actinobacillus pleuropneumoniae. No outro cenário de doença, G. australis causa sinais clínicos em suínos nas granjas, com 12 a 20 semanas de idade, sendo alguns casos fatais.

A pesquisa contínua sobre G. australis levou a um teste de diagnóstico que está sendo validado atualmente. Isso envolve testar 26 isolados de G. australis, 15 cepas de referência e um isolado de A. pleuropneumoniae, 16 cepas de referência para outra bactéria (Pasteurella multocida) que causa doenças respiratórias e outras 47 cepas e isolados de campo representando 12 gêneros e 26 espécies de bactérias semelhantes.
Para determinar a prevalência de G. australis, os pesquisadores analisaram amostras de pulmões com lesões, abscessos e pleurisia de 23 granjas em NSW, 43 em Queensland, uma em Queensland, uma em SA e 27 em Victoria. Esses dados ainda estão sendo analisados.
17 de april 17, 2020/ QAAFI/ Australia.
https://qaafi.uq.edu.au/